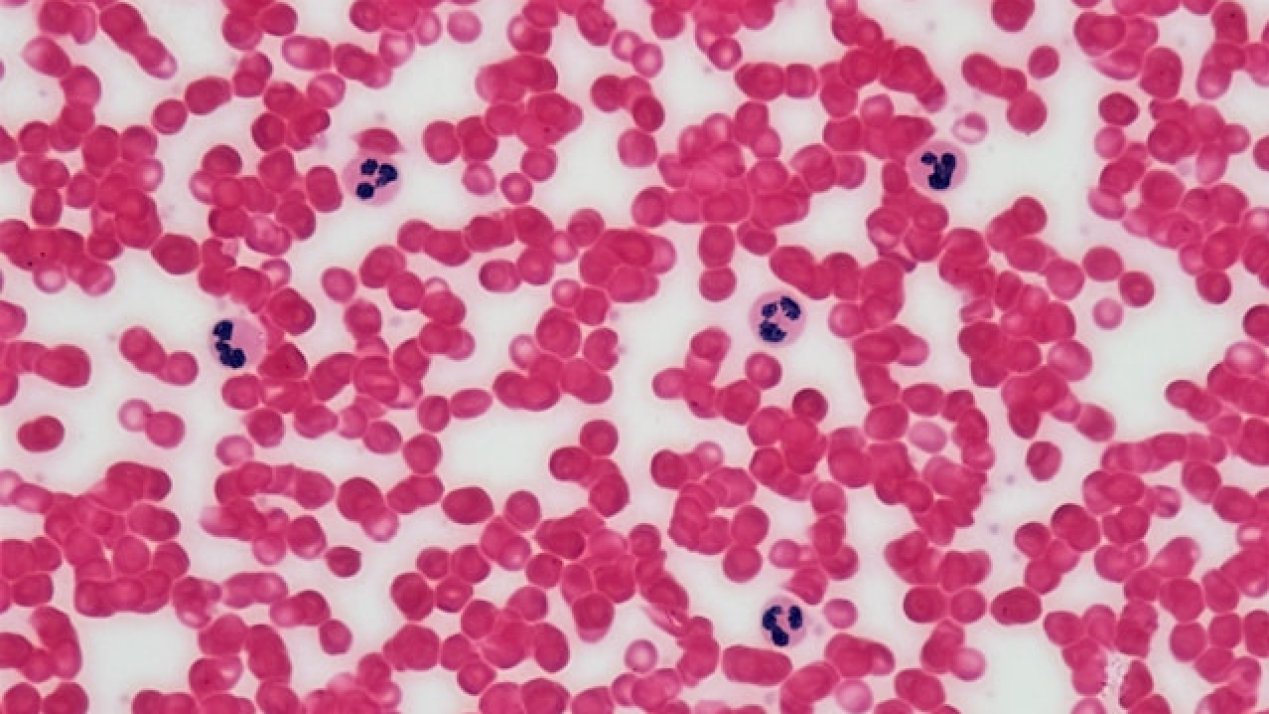
Novo Nordisk to Present New Hemophilia Research

Loading...
Loading...
By MBN Staff - Mon, 01/19/2026 - 09:01
Novo Nordisk México appoints Patricia Field as Director General to strengthen innovation, access to care, and its chronic disease strategy.
https://mexicobusiness.news/tag/novo-nordisk
More Health
By MBN Staff - Fri, 07/18/2025 - 10:26
Fangzhou and Novo Nordisk partner to deliver digital tools for chronic disease management, focusing on diabetes and obesity.
By Sofía Garduño - Thu, 06/12/2025 - 10:00
This week Farmacias del Ahorro entered the pet health market and Alfasigma invested MX$100 million to launch a new business unit. The Week in Health!
By MBN Staff - Mon, 06/09/2025 - 12:02
Novo Nordisk will present new hemophilia A and B phase 3 data at ISTH 2025, including results on Mim8, concizumab, and treatment preferences.
By Sofía Garduño - Thu, 03/06/2025 - 18:43
This week, Mexico and PAHO discussed plans to strengthen regional health systems. Meanwhile, WHO issued 2025-2026 flu vaccine recommendations.
By MBN Staff - Fri, 02/28/2025 - 16:18
Novo Nordisk to launch semaglutide 2.4mg in Mexico for weight management. The drug is designed to aid obesity and overweight treatment.
By Sofía Garduño - Thu, 02/27/2025 - 07:45
This week, Marken rebranded, COFEPRIS and IMPI streamlined pharma registration, and Novo Nordisk resolved an Ozempic shortage in the United States.
By Sofía Garduño - Mon, 02/24/2025 - 11:27
The FDA confirms that US supply of Wegovy and Ozempic now meets or exceeds demand, following Novo Nordisk's US$6.5 billion investment.
By Sofía Garduño - Tue, 02/18/2025 - 13:42
A new survey shows GLP-1 medication access is increasingly important for job retention and hiring, with demand driving employer-sponsored coverage.
By MBN Staff - Tue, 12/03/2024 - 10:37
Canada approves Novo Nordisk’s Wegovy to reduce heart attack risk in obese adults with cardiovascular disease.